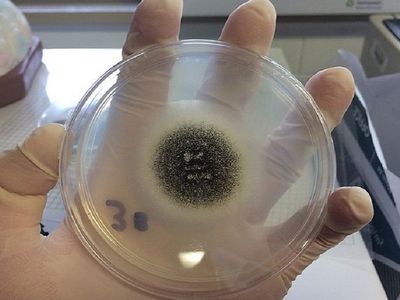
В Египте выявили семь случаев "черной плесени" - Наука и здоровье

Йонинес. Висагинас всретит самую короткую ночь 23 июня
Программа праздника
Загрузка...
--

Именно эту причину назвал Виргиниюс Букаускас, отвечая на вопрос «Зачем понадобилось сносить бетонное основание на ул. Парко?»

Открытие - в 11.00 у «Банги», торжественная часть - в 17.00 в амфитеатре у прогимназии «Gerosios vilties»

Днем будет выше 20 градусов, возможны небольшие дожди, местами с грозами

По данным Висагинского комиссариата полиции, на прошлой неделе было проверено 89 человек

Президент Совета ИКАО призвал заинтересованные государства к тесному сотрудничеству со следствием


Привиться могут все жители с 16 лет

В настоящее время госпитализировано 16 пациентов

В мае прошлого года между странами Балтии был создан "пузырь путешествий"

"В некоторых показателях можно увидеть просто впечатляющие изменения", - профессор Миндаугас Станкунас

Расписание богослужений в Введено-Пантелеимоновском храме
В организм человека грибок чаще всего попадает через аппараты искусственной вентиляции легких.

В МИД республики назвали решение Вильнюса о высылке двух белорусских дипломатов ничем не мотивированной инициативой

Обзор главных событий Литвы за неделю в удобном, доступном и очень коротком блиц-формате


Ремонт уже идет полным ходом, но этот вопрос продолжает интересовать жителей

Годами жители близлежащих домов задыхались от пыли, и, наконец, их жалобы приняты к сведению

На пустыре в III мкр. планируется сделать экспозицию старых малых игровых форм

В Европейском союзе велосипедистов будут рады рассмотреть данное предложение


Įsibėgėja Ignalinos viešosios bibliotekos projektas


В сводке за неделю: о смерти, сдаче оружия, краже, задержании нетрезвого водителя и других инцидентах

Паспорт возможностей" можно скачать на сайте gpasas.lt

В январе-апреле получено на 20 проц. больше доходов, чем за тот же период прошлого года

Установят новые счетчики за 75 млн. евро, счета будут выписывать автоматически

В Литве показатель заболеваемости за 14 дней составляет 467,38, а смертности – 58,7

В Висагинасе должна появиться горка для катания на лыжах, санях и «ватрушках»

«От такого режима можно ожидать чего угодно», - заявила премьер Литвы

О значительном повышении стоимости теплоэнергии и горячей воды